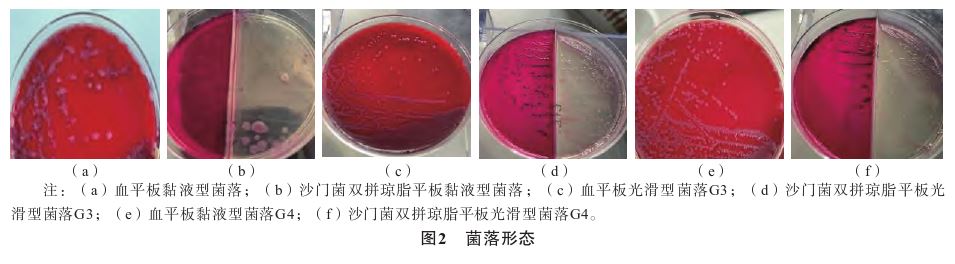
1773276175777738.jpg 1773276175777738.jpg

泌尿道感染样本分离出黏液型肯塔基沙门菌ST198.2-1 1例报道
作者:刘 瑛,陈 峰,李 虎,刘 玥等,上海交通大学医学院附属新华医院检验科,上海市疾病预防控制中心病原生物检定所
沙门菌(Salmonella)是人类重要的感染型食源性病原[1] ,分布于全球的养殖动物(畜禽类)和水产品中,存在物种与优势菌共存[2] 。人经粪-口途径感染沙门菌后,因个体免疫水平差异症状有所不同:低龄幼儿易出现腹泻、腹痛、发烧等典型感染性腹泻
症状;成人可自限,罹患基础性疾病者易经肠系膜静脉系统入血形成菌血症、脓毒血症等重症,甚至死亡[3] 。沙门菌泌尿道感染不常见,危险因素与患者免疫功能低下和潜在的泌尿系统结构异常有关[4-7] 。2023年8月,上海交通大学医学院附属新华医院自1例泌尿道感染患者清洁中段尿样本中首次分离到1株高水平耐药、黏液型的肯塔基沙门菌。该患者急诊就医,临床多次经验用药治疗失败。本文基于全基因组测序(whole genome sequencing,WGS)结果,结合国内外持续流行的高水平耐药肯塔基沙门菌ST198.2-1耐药克隆等报道[8-10] ,对病例进行解析。
1 病例资料
1.1 诊疗过程
患者,女,74岁,患2型糖尿病
近10年。2023年8月6日因尿频、尿急(无发热
、无胸闷气促、无胸痛
腹痛)至上海交通大学医学院附属新华医院急诊就诊。查体:神清,气平,双瞳孔等圆,对光反射正常,鼻唇沟对称,伸舌居中,两肺呼吸音粗,无明显干、湿啰音;心律齐,氧分压98%,腹软,无压痛反跳痛,下肢无浮肿。实验室检测:血常规
示白细胞5.94×109L-1,中性粒细胞百分比45.3%,红细胞4.66×1012L-1,血小板219×109L-1,血红蛋白
140 g·L-1,C反应蛋白5 mg·L-1;尿常规
示黄色浑浊尿液;尿沉渣
镜检示每高倍镜视野80~ 100个白细胞、1~3个红细胞。尿血红蛋白检测示红细胞20个·μL-1,尿糖正常,白细胞酯酶检测示白细胞500个·μL-1,尿蛋白0.75 g·L-1,尿亚硝酸盐阳性;中段尿培养
示沙门菌属
某种生长,呈“黏液型菌落”,菌量>10万 CFU·mL-1。临床诊断为泌尿道感染和2型糖尿病。就诊当日经验用药左氧氟沙星
0.5 g qd联合头孢吡肟
1 g bid (1 d),医嘱如有任何不适及时就诊,泌尿外科门诊随访。患者诊疗进程见图1。
1.2 病原分离和表型鉴定
依据《WS/T 489—2017 细菌性腹泻临床实验室诊断操作指南》[11] 和《WS 271—2007 感染性腹泻诊断标准》[12] 附录B.1,以及第4版《全国临床检验操作规程》[13] 要求进行病原菌分离培养、生化初筛、系统生化鉴定、质谱鉴定、血清分型和体外抗菌药物敏感性试验。沙门菌血清分型按照世界卫生组织/GSS网络实验室标准操作流程[14] 进行O和H相位诱导、抗原鉴定。用纸片扩散法和微量肉汤稀释法分别测试分离株的抗菌药物敏感性,分别参考美国临床实验室标准化协会(the Clinical and Laboratory Standards Institute,CLSI)M100-Ed33文件[15] 和美国国家肠道耐药监测系统共识[16] 判读结果,质控菌株大肠埃希菌(ATCC 25922)由丹麦国立血清研究所提供。
1.3 黏液型肯塔基沙门菌WGS表型预测和基因注释
提取菌株DNA,测定DNA基因组浓度和质量,并构建文库,进行双端150 bp测序;用SPAdes的Unicycler短序列组装软件进行组装,并根据reads中paired end、overlap关系对组装结果进行局部优化;使用GapClose1.2软件对组装结果进行修补,除去冗余序列,获得组装草图。用SeqSero2(1.2.1)和SISTR(4.0.0)[17-18]
2种开源软件预测血清型;通过PubMLST数据库比对多位点序列分型(multilocus sequence typing,MLST)结果。用GeneMarkS分析工具(http://topaz.gatech.edu/GeneMark/genemarks. cgi)预测沙门菌编码基因;通过resFinder数据库对分离株耐药基因进行预测和注释,利用Center for Genomic Epidemiology平台的Mobile Element Finder分析工具(https://cge.cbs.dtu.dk/services/Mobile Element Finder)预测菌株的可移动遗传元件,包括质粒和插入片段;基于VFDB(Virulence Factor Database)数据库对分离株毒力因子进行预测和注释。从中国沙门菌区域血清型数据库[15] 挑选2株光滑型、相同耐药型、相同基因型肯塔基沙门菌ST198.2-1(编号G3、G4,均分离自贵港市覃塘区人民医院2023年同1例无症状体检者)WGS序列作为参考菌,注释比较黏液型和光滑型肯塔基沙门菌的预测基因数异同点。

2 结果
2.1 患者疾病转归
患者于2023年7月9日、7月20日2次因泌尿道感染急诊就诊,均未行尿液细菌培养,医嘱均为左氧氟沙星0.5 g qd联合头孢唑肟
0.5 g bid(1 d);8月6日再次因泌尿道感染就诊,尿液细菌培养结果为沙门菌属某种生长,呈“黏液型菌落”,菌量>10万CFU·mL-1,临床当日根据尿常规结果,医嘱仍为左氧氟沙星0.5 g qd联合头孢唑肟1 g bid(1 d)。至投稿前,经电话随访,患者自觉泌尿道感染基本痊愈,因行动不便拒绝再次行尿液细菌 培养。
2.2 基于培养的病原分离和表型鉴定
取1 μL尿液直接接种于血琼脂平板用于计数;另取10 mL尿液,离心后取沉淀物接种于血琼脂平板,(36±1)℃培养18~24 h,挑取单个黏液型菌落[图2(a)],经质谱初步鉴定为沙门菌属,计数菌量>10万CFU·mL-1,将初步结果报告临床。另挑取血琼脂平板上单个菌落接种于水解酪蛋白
肉汤,用于体外药物敏感性试验和纯化,(36±1)℃培养18~24 h,木糖赖氨酸
脱氧胆盐琼脂平板上菌落直径>3 mm、扁平干燥,平板边缘见硫化氢样黑色菌苔;沙门菌双拼琼脂平板上菌落直径>3 mm、淡紫红色、略干燥,呈不规则样,个别菌落呈露滴状[图2(b)],生化表型均符合沙门菌定义:葡萄糖
⊕、甘露醇
⊕、 蔗糖
-、动力+、硫化氢+、吲哚-、尿素
-。纯化后菌落氧化酶试验
阴性、革兰染色结果为阴性短杆菌,系统生化鉴定为沙门菌属。将培养物继续接种于哥伦比亚琼脂基础斜面和Ⅰ型诱导培养基,(36±1)℃培养18~24 h,根据菌体抗原(O相)和鞭毛抗原(H相)对应培养物与抗血清特异性凝集结果鉴定为肯塔基沙门菌(6,8:i:z6)。分离菌株经上海市疾病预防控制中心肠道参比实验室复核。用于基因组比较的2株光滑型肯塔基沙门菌ST198.2-1同等条件下血琼脂平板和沙门菌双拼琼脂平板的菌落特征见图2(c)~(f)。
2.3 体外药物敏感性试验结果
分别用纸片扩散法(临床实验室)和微量肉汤稀释法(公共卫生实验室)先后测试该分离株对9种和29种抗菌药物的敏感性。2种方法结果均为耐药的抗菌药物为环丙沙星
、头孢曲松
、氨苄西林
,均为敏感的抗菌药物为氯霉素
、复方磺胺甲噁唑
。微量肉汤稀释法敏感的药物除氯霉素、复方磺胺甲噁唑外,还有氨基糖甙类(阿米卡星
、庆大霉素
)、大环内酯类、青霉烯类、黏菌素类、替加环素
类抗菌药物,加酶抑制剂结果提示菌株产超广谱β-内酰胺酶
(extended-spectrum beta-lactamase,ESBL)。
2.4 基于WGS的多维度预测和与光滑型肯塔基沙门菌基因组比较结果
经2种软件预测,黏液型肯塔基沙门菌WGS序列血清型和血清分型结果一致,MLST结果均为ST198;resFinder数据库注释的耐药基因为氨基糖苷类[aac(6')-Iaa]、ESBL(blaCTX-M-14b) 和喹诺酮类药物耐药决定区(q u i n o l o n e resistance determining region ,QRDR)存在2个基因双点突变[gyrA(S83F/D87G)、parC(T57S/S80I)];黏液型肯塔基沙门菌ST198基于VFDB数据库注释的毒力基因有105个(相似度≥80%),其中分泌系统相关毒力因子最多(74个),其次为菌毛黏附(20个);携带1个质粒复制子ColRNAI。2株光滑型肯塔基沙门菌较黏液型携带的耐药基因种类更多,2株光滑型肯塔基沙门菌的毒力基因数(相似度≥80%)均为107个,其中105个基因覆盖黏液型基因:黏液型和光滑型肯塔基沙门菌间分泌系统相关毒力基因数相同,均为74个,光滑型肯塔基沙
门菌的菌毛黏附基因(22个)较黏液型肯塔基沙门菌多2个:即黏液型肯塔基沙门菌缺失2个菌毛调节蛋白基因(papI、papB)。2株光滑型肯塔基沙门菌的质粒复制子个数分别为1个(Col156)和2个(Col156、Col8282)。
3 讨论
肯塔基沙门菌通过受污染的食品,特别是家禽产品引起人类感染[8-9] 。欧洲疾病预防控制中心数据显示,2018—2020年,肯塔基沙门菌一直是人类临床沙门菌病居前20位的血清型之一[19] 。
上世纪90年代以前,肯塔基沙门菌对抗菌药物敏感,后来进化出染色体
携带多种抗菌药物耐药基因嵌入沙门菌基因组岛1(SGI1-K)变异菌型[20] 。2002年法国报道了首例耐环丙沙星的肯塔基沙门菌[21] ,随即向全球扩散。目前,欧洲、美洲、亚洲和非洲等地皆有病例被报道[22-23] 。
肯塔基沙门菌是一种能感染不同宿主的生态多源化菌型,主要有3种MLST型别:ST198、ST152和ST314。ST314来源较复杂,包括牛、家禽、宠物、动物性食品和人类;ST152也与人类疾病有关,但20年来仅在家禽中被分离到(美国),在无症状牛中也有报道;ST198多来自鸡和人,基于核心基因组单核苷酸多态性聚类分析,近10年来,ST198分化为ST198.1和ST198.2这2个分支,ST198.1来自美洲,ST198.2来自亚洲、欧洲、美洲、中东的人类、食品和鸡[24] 。ST198.2在我国继续分化为ST198.2-1和ST198.2-2这2个亚分支[24-25] 。2019年以前,ST198.2-1是我国浙江、广西、湖南等地人群和鸡群传播的优势亚型(流行株)[25] 。2019年后,ST198.2-2再次获得1个多耐药区,增强了其对β-内酰胺类、氨基糖苷类、酰胺醇、替加环素、阿奇霉素
和磷霉素
的耐药性,均在我国的鸡群和人群中上升为优势进化群,有替代之前流行的ST198.2-1分支的趋势[24] 。多药耐药区机制可帮助ST198.2-2升级为泛耐药沙门菌,鸡是该新克隆的主要宿主[24] 。
本研究回顾上述全球多重耐药沙门菌中具有重要影响力的肯塔基沙门菌ST198的各分支的时空基因组耐药流行病学资料,发现上海市2019年之前优势肯塔基沙门菌是仅对环丙沙星耐药的ST198.1,本例患者感染的肯塔基沙门菌对三代头孢菌素高水平耐药(头孢他啶
>64 μg·mL-1、头孢吡肟>32 μg·mL-1),与过去流行的ST198.1的耐药表型不同。ESBL是肠杆菌科细菌(包括大肠埃希菌、沙门菌和肺炎
克雷伯菌)对β-内酰胺类抗菌药物耐药的主要机制。比较基因组学证实blaCTX-M-14b基因在肯塔基沙门菌染色体上,位于Ⅵ型分泌系统区域[25] 。 blaC TX-M-14b基因整合在hcp1基因的下游,在含有ISEcp1的2 854 bp的质粒片段上[9] 。blaC TX-M-14b克隆可能起源于2005年的埃及[9] 。多数肯塔基沙门菌ST198.2对氨苄西林、头孢唑林
和头孢噻肟
耐药,CTX-M-14b和CTX-M-55的不同酶型可区别于ST198.2-1和ST198.2-2;ST198.2-1的QRDR区域gyrA双点突变S83F/D87G不同于ST198.2-2双点突变S83F/D87N[24] 。由此判断,本例患者泌尿道感染的肯塔基沙门菌属于典型ST198.2-1亚分支,其高水平耐药特征与其染色体携带耐药基因blaCTX-M-14b和gyrA(S83F/D87G)、parC(T57S/S80I)的表达存在因果关系。
已知的沙门菌表型变异包括粗糙型、黏液型、单相变种、硫化氢阴性,罕见的沙门菌表型变异往往给临床精准诊断带来不可忽视的困惑和挑战,除依靠参比实验室外,更要关注表型变异菌是否具有作为优势克隆形成公共卫生事件的可能性[14,26-27] 。本次从我国沙门菌区域血清型数据库挑选同耐药型、同分子型的肯塔基沙门菌ST198.2-1光滑株预测结果显示,黏液型肯塔基沙门菌缺失2个菌毛调节蛋白基因papI、papB,预判该菌因菌毛调控蛋白缺失变异而形成黏液型,可理解为细菌在尿道环境生存压力下的适应性进化结果。查证该耐药型克隆,发现其于2020年被欧洲疾病预防控制中心预警,对泌尿道的易感性特征目前位居所有非伤寒沙门菌之首(14.1%),该菌株高水平耐药所致泌尿道感染具有更难根除、易复发的临床特征[10] 。
质粒组分析显示,本例患者感染的黏液型肯塔基沙门菌携带的质粒ColRNAI是我国肯塔基沙门菌ST198.2-1中最多见的质粒型[25] 。 深圳报道的15株肯塔基沙门菌ST198.2-2对环丙沙星耐药性更高(MIC≥32 μg·mL-1),耐药机制与质粒介导喹诺酮耐药基因qnrS1先整合在IncHI2质粒,然后转入染色体表达,是我国首次报道染色体介导blaCTX-M-14b和qnrS1的XDR肯塔基ST198.2-2亚分支[28] 。质粒介导抗菌药物耐药的严重性低于染色体介导的耐药性。质粒可以获得,也可在细菌进化过程丢失;减少抗菌药物使用也可减少对细菌的选择压力,导致质粒从种群中消失[10,29] 。染色体介导抗菌药物耐药性的生态意义更严重,基因一旦整合进细菌染色体,极可能是不可逆的,且无限期,尤其是在基因未给细菌形成进化压力的情况下。
环丙沙星和超广谱头孢菌素是我国临床治疗成人和儿童非伤寒沙门菌感染
最优先选用的抗菌药物[25] 。同时,环丙沙星和头孢菌素耐药沙门菌也是全球严重的公共卫生问题。2017年,耐氟喹诺酮沙门菌和产ESBL肠杆菌被世界卫生组织列为危害人类健康的重要病原体之一[30] 。本例患者是我国首次确诊罹患基础疾病老年人泌尿道感染多重耐药肯塔基沙门菌ST198.2-1病例,该菌缺失2个菌毛调节蛋白基因后变异为黏液型,这给实验室诊断带来一定困难;另外,高水平耐药肯塔基沙门菌会影响泌尿道感染的根治,其易复发的临床特征将带来较大的疾病负担。美国国立卫生院2023年2月发布了针对女性泌尿道细菌感染的4种灭活菌混合疫苗(大肠埃希菌、肺炎克雷伯菌、普通变形杆菌、粪肠球菌),并投放于 26个国家[31] 。需要注意的是,疫苗作为科技进步的产物,即使有效,也不可忽视细菌自身物竞天择的进化本质。
上海作为我国高人口老龄化率的城市之一,继欧盟之后,临床首次确诊泌尿道感染肯塔基沙门菌ST198.2-1病例,其临床新病原特征和疾病负担问题值得关注。应对耐药性更强的肯塔基沙门菌ST198.2-2,即使是临床治疗多重耐药革兰阴性菌感染最后措施之一的替加环素也会失效[10,24,32] 。临床面对多重耐药沙门菌的挑战,需加强多学科沟通和对黏液型肯塔基耐药表型监测,关注阿奇霉素、替加环素耐药和blaO XA-1、bla TEM-1b等耐药基因。建议利用国家级和全球沙门菌基因组数据库[17-18,33] 溯源临床沙门菌时空基因组和耐药流行病学特征。
参考文献略。
来源:刘瑛,陈峰
,李虎
,等. 泌尿道感染样本分离出黏液型肯塔基沙门菌ST198.2-1 1例报道[J]. 检验医学,2025,40(10):1030-1034.